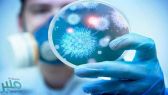
جدل واسع بشأن انتشار “كورونا” عبر الهواء.. و”الصحة العالمية” تحسم الجدل

دخلت الإعلامية اليمنية ومذيعة قناة ” الحدث ” أسماء راجح، في نوبة بكاء على الهواء بسبب الأوضاع المأساوية ببلدها.
وأظهر مقطع الفيديو أسماء راجح حزينة ولم تتمكن من السيطرة على دموعها بسبب الأوضاع في بلادها.
وبدا في المقطع تأثر راجح بمحتوى التقرير الذي بثته وتسبب في فيضان دموعها حزنا على ما وصلت إليه بلادها.
وتحدثت راجح عن سبب بكائها، قائلة: ” بكيت وطني المذبوح، بكيت كرامة أمي في بقايا مكان، بكيت الأطفال وهم لا يملكون قرارا ولا حلما قريبا”.